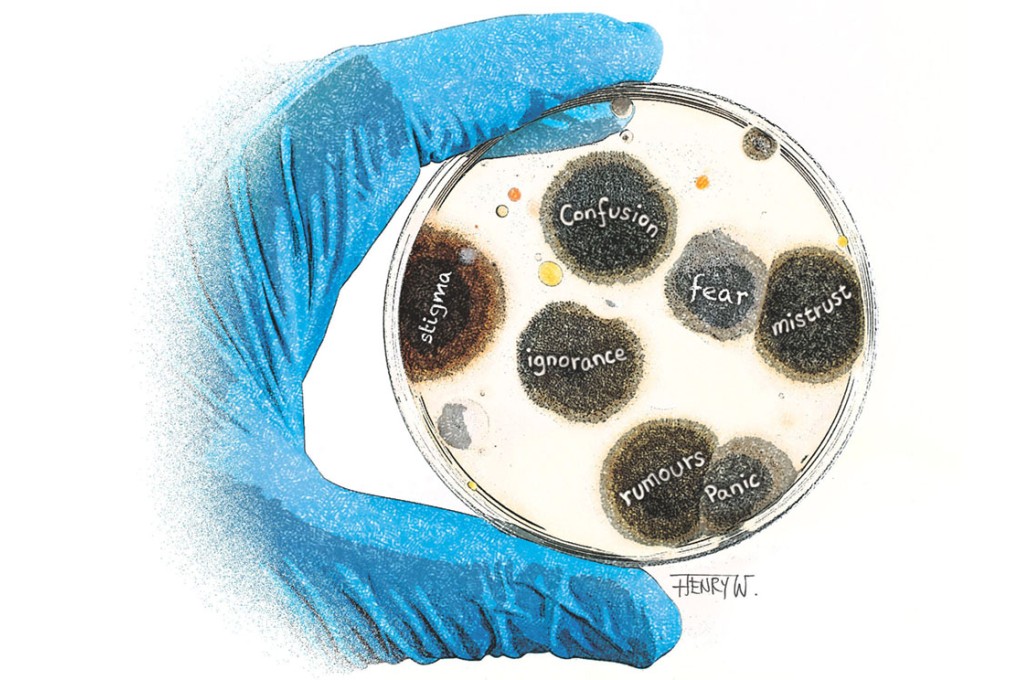
The fear bug

Waging battle on Ebola, and an outbreak of fear and confusion
Eliza Cheung says the outbreak of the deadly Ebola virus in West Africa is being worsened by a lack of knowledge and the spread of inaccurate information, hampering the medical response
Not long after I arrived in Monrovia, the capital city of Liberia, one expatriate working here told me: "I am in a panic now. I just found out that I shook hands with someone last week who had contact with a confirmed Ebola patient. What should I do?"
In the three weeks I've been here, as part of a Red Cross mission seeking to contain an outbreak of Ebola in West Africa, I've come across many such stories about fear, as well as those of grief and despair.
This fear is understandable.
The Ebola virus is deadly. In previous outbreaks, as many as 90 per cent of those infected have died, though early intervention can dramatically improve the chances of survival. Once infected, patients developed symptoms such as fever, vomiting, diarrhoea and internal bleeding. There is no proven vaccine or cure, and treatment involves giving the patient supportive care - replacing lost fluids and controlling fever - to help the immune system fight off the virus.
Transmission is relatively difficult, however, and only occurs through direct contact with bodily fluids of an infected patient.
So far, the current outbreak in Liberia, Guinea and Sierra Leone has infected more than 1,700 people and killed over 900, and the World Health Organisation has warned that it could get worse.